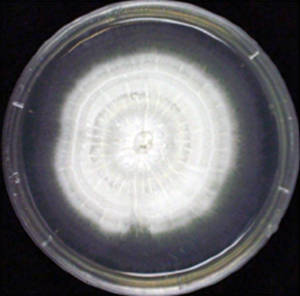
テルペンドールE生産菌のコロニーの図

2012年12月21日
独立行政法人理化学研究所
抗がん剤の種「テルペンドールE」の生合成メカニズムを解明
-テルペンドールEはかび毒生合成のカギとなる中間体だった-
ポイント
- テルペンドールEとかび毒の生合成に関与する遺伝子を7個同定
- テルペンドールEを変換する酵素の遺伝子を欠損させ、安定的調製が可能に
- 副作用が少ない新しい抗がん剤開発やかび毒制御への応用に期待
要旨
理化学研究所(野依良治理事長)は、土壌に棲む糸状菌※1の仲間が、新しい抗がん剤の種となる化合物として注目されている「テルペンドールE」を生合成するメカニズムを明らかにしました。これは、理研基幹研究所(玉尾皓平所長)長田抗生物質研究室の長田裕之主任研究員、本山高幸専任研究員らの研究チームによる成果です。
糸状菌は、世界初の抗生物質として有名なペニシリンや、血中コレステロール低下薬剤のスタチンなどを生産する能力を持つため、医薬の種となる化合物の主要な供給源となってきました。しかし、その有用物質を得るためにそれを生産する糸状菌を単離して試験管内で純粋に培養すると、有用物質を生産しなくなる現象が頻繁に起きるため、糸状菌から有用物質を安定に生産する手法の開発が求められています。2003年に、研究チームが糸状菌から単離したテルペンドールEは、副作用が少ない抗がん剤の種となる化合物として注目されていますが、糸状菌による生産が安定しないうえ、化学構造が複雑で人工的な有機合成が難しいため、創薬研究はなかなか進みませんでした。
研究チームは、テルペンドールEと構造が似ている3個のかび毒※2に注目し、既知であるそれらの生合成遺伝子情報を参考に、テルペンドールEを生産する糸状菌から7個の生合成遺伝子の単離に成功しました。これらの遺伝子を欠損させたり、単独で発現させたりして生合成経路を解析したところ、テルペンドールEは、かび毒として知られるテルペンドールC※3が合成される前に一時的にしか存在しない生合成中間体※4の1つであり、その結果、テルペンドールEの生産が不安定になると分かりました。そこで、7個の遺伝子のうちテルペンドールEを次の生合成中間体に変換する酵素の遺伝子「terP」を欠損させたところ、テルペンドールEを安定的にかつ大量に調製することができました。
今回、テルペンドールEの生合成メカニズムを明らかにしました。これにより、テルペンドールEの人為的で安定的な大量生産が可能になります。また、この知見によりテルペンドールCだけでなく、類似の構造を持ち家畜に重大な被害を及ぼすロリトレムB※5などのかび毒の生産制御が可能になると期待できます。
本研究成果は、農業・食品産業技術総合研究機構生物系特定産業技術研究支援センターのイノベーション創出事業などの支援を受けて得られたもので、米国の科学雑誌『Chemistry and Biology』(12月20日号)に掲載されます。
背景
糸状菌は、主に土壌中に存在し、二次代謝産物を生産する微生物として知られています。抗生物質として有名なペニシリンや、血中コレステロール低下薬剤のスタチンなどの有用物質を生産する能力を持つため、医薬や農薬の種となる化合物の主要な供給源の1つです。しかし、その有用物質を得るために糸状菌を単離して試験管内で純粋に培養すると、有用物質を生産しなくなる現象が頻発することから、安定に生産する手法の開発が求められています。一方、糸状菌は、肝細胞がんの原因物質のアフラトキシンや食中毒の原因の1つであるトリコテセンなどのかび毒も生産するため、かび毒を制御する手法の開発も課題になっています。
2003年に研究チームは、埼玉県秩父市の土壌から単離した糸状菌(Chaunopycnis alba RK99-F33)が生産する「テルペンドールE」(図1)が、抗がん剤の標的分子の1つであるキネシンEg5※6を阻害することを見いだしました。キネシンEg5の阻害は、他の標的分子を阻害することに比べ副作用が少ないため、テルペンドールEは、副作用が少ない新しい抗がん剤の種となる物質として注目されています。しかし、糸状菌によるテルペンドールEの生産が安定しないため化合物の大量生産が困難で、かつ構造が複雑で人工的な有機合成も難しく、創薬研究はなかなか進んでいませんでした。同時に、Chaunopycnis alba RK99-F33(テルペンドールE生産菌、図2)は、類似の構造のかび毒「テルペンドールC」(図1)も生産するため、その生産制御が求められています。テルペンドールCは、家畜に重大な被害を及ぼす強力なかび毒で牧草の汚染を引き起こす「ロリトレムB」(図1)と構造が似ているので、テルペンドールCの生合成メカニズムを明らかにすることができれば、構造が類似したさまざまなかび毒の生産制御が可能になるとも期待されていました。そこで研究チームは、テルペンドールEの生合成メカニズムの解明に挑みました。
研究手法と成果
まず、研究チームは、テルペンドールE生産菌を純粋に培養して経時的に生産される化合物を分析したところ、テルペンドールEがごく一時的に生産され、すぐに消失し、その後、テルペンドールCが生産されることを見いだしました。この結果から、純粋に培養したテルペンドールE生産菌は生産能を失っておらず、テルペンドールEはテルペンドールCの生合成中間体であると予想しました。この仮説を証明するために、テルペンドールEとテルペンドールCの生合成に関与する遺伝子を単離して解析しました。テルペンドールEと構造が似たかび毒のパキシリン、アフラトレム、ロリトレムBの既知である生合成遺伝子情報を参考に、テルペンドールE生産菌から7個の生合成遺伝子(terP、terQ、terK、terM、terB、terC、terF)の単離に成功しました。これらの遺伝子のうち、terPを破壊するとテルペンドールEが大量に蓄積するようになったため、terPの遺伝子産物がテルペンドールEの変換に関与していることが明らかになりました。また、同時にかび毒のテルペンドールCが蓄積しなくなったため、テルペンドールEはテルペンドールCの生合成に重要であることも分かりました。
次に、研究チームは、terPの遺伝子産物の詳細な反応を明らかにするため、terP以外の6個の生合成遺伝子を全て取り除いた変異株を純粋に培養し、培養液にテルペンドールEを滴下しました。その結果、テルペンドールEは新規化合物(13-デスオキシテルペンドールI、図3 左の経路)に変換されました。さらに、terQ以外の6個の生合成遺伝子を全て取り除いた株を純粋に培養し、培養液に13-デスオキシテルペンドールIを滴下しました。その結果、13-デスオキシテルペンドールIはさらに別の化合物(テルペンドールCの生合成中間体)に変換されました。
更に、研究チームは、テルペンドールEの生合成経路を明らかにするために、terQ以外の6個の生合成遺伝子を全て取り除いた株を純粋に培養し、培養液に3個のかび毒に共通する生合成中間体パスパリン(図3)を滴下しました。その結果、パスパリンがテルペンドールEに変換されたことから、テルペンドールEはパスパリンから酵素TerQの働きで合成されることが明らかになりました。
以上の結果から、テルペンドールEがテルペンドールCの生合成におけるカギとなる中間体であることが明らかになり(図3 左の経路)、生合成中間体は一時的生産物であるために、テルペンドールEの生産が不安定になると分かりました。
今後の期待
今回、テルペンドールEを直接的に別の化合物へと変換させる酵素の遺伝子terPを欠損させると、安定的な大量生産が可能になると分かりました。これにより、副作用の少ない新しい抗がん剤の創薬研究が進展すると期待できます。今後、同定した7個の生合成遺伝子を操作することで、テルペンドールEより効果が高い化合物を、安定的に大量に生産できる可能性があります。
ロリトレムBは、テルペンドールCと構造が似ていることが分かっており、研究チームは、ロリトレムB生産菌も生合成中間体としてテルペンドールEを生産していると予想しています(図3)。従って、ロリトレムBとテルペンドールCの生合成経路がよく似ていることから、テルペンドールCだけでなく、ロリトレムBなどのかび毒の生産制御も可能になると期待できます。
原論文情報
- Takayuki Motoyama, Toshiaki Hayashi, Hiroshi Hirota, Masashi Ueki, and Hiroyuki Osada.
"Terpendole E, a Kinesin Eg5 Inhibitor, Is a Key Biosynthetic Intermediate of Indole-Diterpenes in the Producing Fungus Chaunopycnis alba".
Chemistry and Biology, 2012,doi: 10.1016/j.chembiol.2012.10.010
発表者
理化学研究所
基幹研究所 長田抗生物質研究室
主任研究員 長田 裕之(おさだ ひろゆき)
専任研究員 本山 高幸(もとやま たかゆき)
報道担当
理化学研究所 広報室 報道担当
Tel: 048-467-9272 / Fax: 048-462-4715
補足説明
- 1.糸状菌
微生物の一種。菌類のうち、菌糸と呼ばれる糸状の細胞を形成するものの総称。かびとも呼ばれ、主に土壌中に棲息する。医薬や農薬の種となる二次代謝産物の生産能が高く、醸造などの食品工業でも広く利用される一方で、植物や動物の病原菌としても知られる。 - 2.かび毒
マイコトキシンとも呼ばれ、糸状菌の二次代謝産物として生産される毒の総称。アフラトキシン、トリコテセンなどが知られ、農産物の汚染による健康被害や植物病害を引き起こすため経済的損失が大きく問題となっている。 - 3.テルペンドールC
テルペンドールE生産菌が生産するかび毒。テルペンドールEと類似の構造であるが、キネシンEg5阻害活性を持たない。 - 4.生合成中間体
生物が酵素を用いて代謝産物を合成する際の途中の物質。 - 5.ロリトレムB
テルペンドールE生産菌と進化的に近縁の植物内共生糸状菌が生産する強力なかび毒。テルペンドールCと非常によく似た構造を示す。この糸状菌が感染した牧草はロリトレムBを生産し、羊などが食べると痙攣(けいれん)を引き起こす。 - 6.キネシンEg5
細胞が分裂する際に、染色体を分離するために、中心体が細胞の両極へと移動する。キネシンEg5は中心体を両極に移動させる際に働くモータータンパク質である。キネシンEg5阻害剤は細胞分裂を阻害することにより、がん細胞の増殖を停止させ、細胞死を引き起こす。同様に細胞分裂を阻害する抗がん剤では、神経障害などが副作用として問題になっているが、キネシンEg5はそのような副作用を引き起こさない抗がん剤の標的分子として注目されている。

図1 テルペンドールEおよび類似化合物の化学構造
図2 テルペンドールE生産菌のコロニー
およそ2週間純粋培養したテルペンドールE生産菌。菌の名前「Chaunopycnis alba RK99-F33」のalbaは「白い」を意味し、白いコロニーを形成する特徴がある。

図3 かび毒生産における2種類の経路
テルペンドールE生産菌の生合成中間体(13-デスオキシテルペンドールI)は、C11-C12エポキシドという構造を持つ(左の経路)。ペンドールE生産菌と進化的に近いロリトレムB生産菌が生産するロリトレムBもこのC11-C12エポキシド構造を持つため、ロリトレムB生産菌はテルペンドールEを生産している可能性がある。
一方、テルペンドールE生産菌と進化的に離れた糸状菌は、テルペンドールEと共通の生合成中間体(パスパリン)を持ち、かつ類似の構造を持つかび毒のパキシリンやアフラトレムを生産する(右の経路)。しかし、これらパキシリンやアフラトレムの生産菌は、テルペンドールEを生産せず、対応する場所にC11-C12二重結合という構造を持つ別の化合物(13-デスオキシパキシリン)を生合成中間体として生産する。
